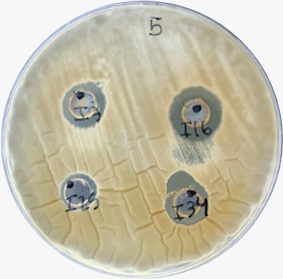
Generalitat tweet media

Generalitat retuiteado

⚠️El nivell de preemergència per risc d'incendi forestal hui 13/04 és:
🔴Extrem a l’interior nord i tot el litoral de Castelló
🟠Alt a l’interior sud de Castelló i interior de València
🟢Baix-mitjà a la resta de la Comunitat Valenciana
#JoDicStopAlFoc

Català